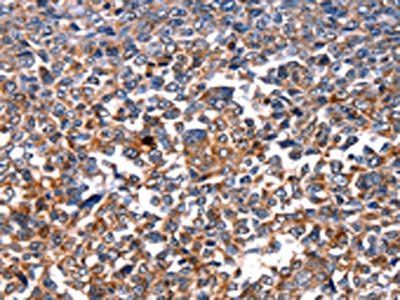
HSPD1 Antibody

You have no items in your shopping cart.
- HSP 90 (Acetyl Lys435) Polyclonal Antibody [orb1416048]
WB
Human, Mouse, Rat
Rabbit
Polyclonal
Unconjugated
100 μl - Human HSP90AA1 protein [orb604170]Featured

Greater than 90% as determined by SDS-PAGE.
41.2 kDa
E.coli
20 μg, 100 μg, 1 mg - Human HSP90AA1 protein [orb605338]Featured

Greater than 90% as determined by SDS-PAGE.
27.2 kDa
Yeast
20 μg, 1 mg, 100 μg - Bacteria hspX protein [orb595063]Featured

Greater than 85% as determined by SDS-PAGE.
18.1 kDa
Baculovirus
1 mg, 20 μg, 100 μg - HSP90AB1 Antibody [orb671062]
ELISA, IF, IHC, IP, WB
Human, Monkey, Mouse, Rat
Rabbit
Polyclonal
Unconjugated
100 μg, 50 μg





_orb240255_wb_1.jpg)